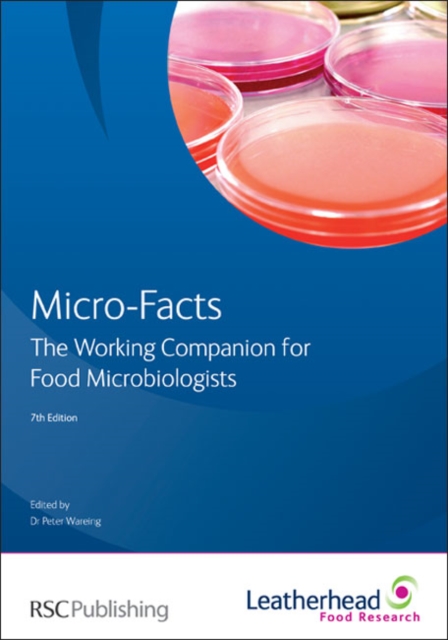
Micro-facts

Micro-facts
The new seventh edition of Micro-Facts has been fully reviewed and updated to incorporate changes in the technical literature. A key change in the seventh edition is the addition of new sections on mycotoxins, food-spoilage yeasts, and factors affecting the growth of micro-organisms. A glossary of microbiological terms has also been added, together with information on twelve food-spoilage moulds t...
The new seventh edition of Micro-Facts has been fully reviewed and updated to incorporate changes in the technical literature. A key change in the seventh edition is the addition of new sections on mycotoxins, food-spoilage yeasts, and factors affecting the growth of micro-organisms. A glossary of microbiological terms has also been added, together with information on twelve food-spoilage moulds t...
